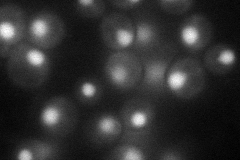
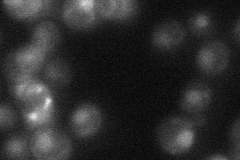
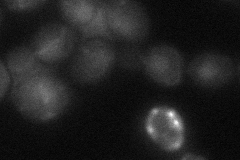

View description
Histone acetyltransferase critical for cell survival in the presence of DNA damage during S phase; acetylates H3-K56 and H3-K9; involved in non-homologous end joining and in regulation of Ty1 transposition; interacts physically with Vps75p
Localization:
Intensity:
Fold change:
Significance:
-
C’ GFP library in SD

below threshold16.32 -
N' NOP1pr-GFP in SD
nucleus65.2826 -
N' TEF2pr-mCherry in SD

cytosol38.6705 -
N' NATIVEpr-GFP in SD
nucleus23.2736 -
N' TEF2pr-VC and Cyto-VN in SD
nucleus30.3744 -
C’ GFP library in SD+DTT

cytosol15.840.97No -
C’ GFP library in SD+H2O2

cytosol17.321.06No -
C’ GFP library in Starvation Media

cytosol16.220.99No -
C’ GFP library on the background of Pup2-DaMP

below threshold -
C’ GFP library on the background of CCT mutant

below threshold17.0861.04609No
